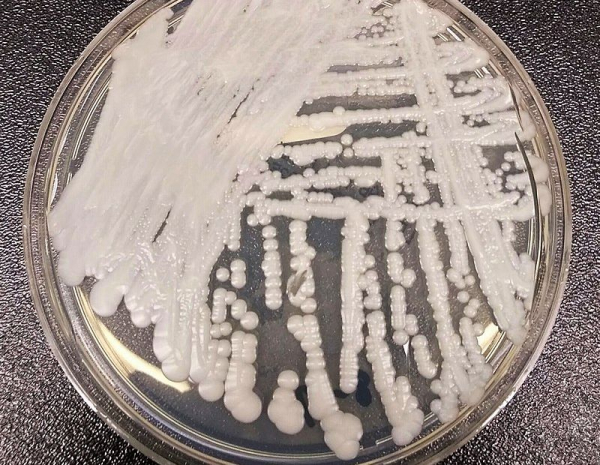

«Из здорового в скелет»: новая грибковая инфекция превращает людей в развалины. ВОЗ бьет тревогу

Фото: pixabay.com
Симптомы, как простуда, но последствия смертельные — новая грибковая угроза может стать пандемией.
Глобальная угроза, о которой раньше говорили лишь специалисты, сегодня становится реальностью — микроскопические грибки рода Coccidioides вызывают всё больше тревоги среди медиков по всему миру. Вот и ВОЗ бьет тревогу и внесла этот вид грибка в список мировых угроз.
Микроскопические грибки рода Coccidioides — это невидимые споры, обитающие в сухих почвах юго-запада США, Мексики и части Южной Америки. Они способны провоцировать тяжёлое заболевание — кокцидиоидомикоз, также известный как «лихорадка долины». И хотя распространение инфекции пока ограничено, врачи не исключают: очень скоро она может стать международной проблемой.
Попав в организм через дыхание, споры грибка могут поражать лёгкие, кожу, кости и даже головной мозг. Болезнь протекает тяжело, требует длительного и токсичного лечения, а симптоматика — от кашля и лихорадки до сыпи и болей в груди — нередко маскируется под обычную простуду, усложняя диагностику. Особенно уязвимы к инфекции люди с ослабленным иммунитетом — пациенты с ВИЧ, онкобольные, пожилые.
Ярким примером последствий стал Торренс Ирвин из Калифорнии, вдохнувший споры на собственном участке. Он стремительно потерял вес и признался: «превратился в подобие скелета».

Иллюстрация: pixabay.com
Другой случай — Роб Перди, у которого развился грибковый менингит с высокой летальностью.
Перди рассказал, что примерно у 3% инфицированных людей грибок распространяется в другие части тела, помимо лёгких, — на кожу, кости и суставы, а также на другие органы или в такие необычные места, как глазное яблоко, зуб и мизинец.
«В половине случаев это приводит к поражению мозга, как в моём случае, — цитирует Пёрди телекомпания CNN. — Чтобы контролировать свою болезнь до конца жизни, я должен делать внутричерепные инъекции токсичным препаратом 80-летней давности, который медленно отравляет меня».
Ситуация осложняется тем, что эффективных лекарств против грибков мало — всего около 17 на фоне сотен антибиотиков. Как объясняет доктор Нил Клэнси из Питтсбургского университета, грибы генетически ближе к человеку, чем бактерии, поэтому лекарства, убивающие грибок, часто вредят и здоровым клеткам. Например, один из самых действенных препаратов может вызывать почечную недостаточность. Среди побочных эффектов также — панкреатит, поражение печени, тяжёлые аллергии и импотенция.
Грибок под микроскопом. Иллюстрация: Shawn Lockhart, CDC
Профессор Дмитрий Кулиш из Сколтеха подчёркивает, что грибковые инфекции могут развиваться как на фоне слабого иммунитета, так и из-за его избыточной реакции. После COVID-19 особенно часто стали фиксировать случаи так называемого «чёрного грибка», который учёным удалось быстро изучить и найти средства борьбы. Но новый вызов может быть сложнее.
В числе наибольших угроз — Cryptococcus neoformans, вызывающий смертельный менингит. Этот патоген уже возглавил список ВОЗ как один из наиболее приоритетных для разработки новых препаратов. Летальность инфекции — более 50%.
Эксперты подчёркивают, что несмотря на отсутствие грибковой пандемии в привычном понимании, устойчивость этих патогенов к лекарствам и их агрессивность делают проблему исключительно опасной. В мире, где всё больше людей с уязвлённой иммунной системой, внимание к грибковым заболеваниям должно быть не меньше, чем к вирусным.
Ранее были названы смертельные болезни, которые угрожают миру прямо сейчас.


